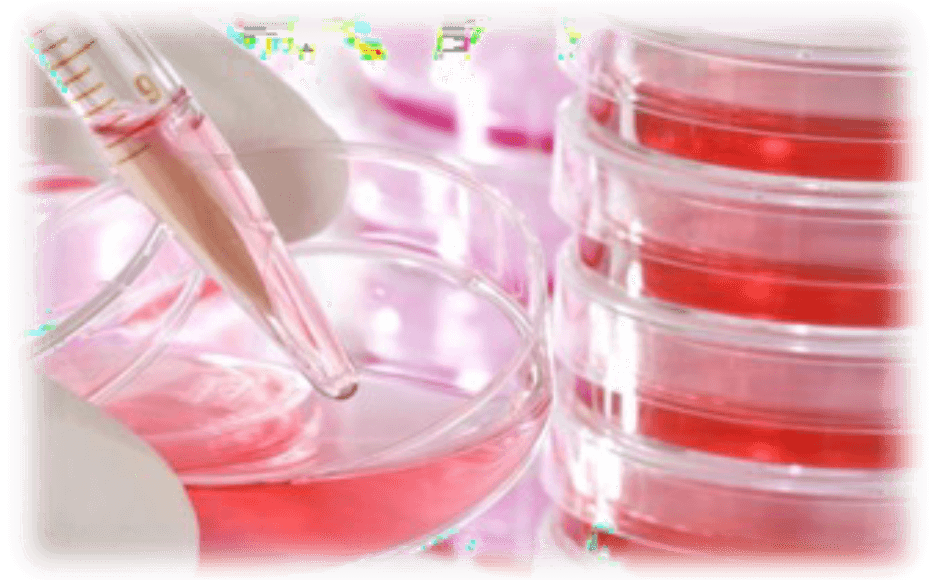

エクソソーム注射(幹細胞培養上清)とは

■エクソソーム注射( 幹細胞培養上清): 再生医療とは
さまざまな臓器、組織が怪我や病気でその機能が失われた時、失われた機能を再生するために、細胞や組織を移植して臓器や組織の機能を元に戻してあげる医療の事です。
この組織再生過程の中で重要な役割を担っている細胞が「幹細胞」です。
「幹細胞」は自らを無限に増殖させる能力( 自己複製能) と特定の組織に分化、つまり変身出来る能力( 多分化能) を持つ細胞の集団です。これら細胞の能力と特性を充分に理解し活用する事により、生体組織の自己再生能力を引き 出し臓器機能の回復をさせる事で、怪我や疾病を治療します。- ・幹細胞の数が非常に少ない
・普段は眠っていて、なかなか覚醒しない
・損傷器官が元に戻る過程は複雑で、
年齢とともに完全でなくなる - 有効活用のため
臨床研究・試験
近い将来に
再生医療の実現
- ・幹細胞の数が非常に少ない

エクソソーム注射/幹細胞とは

■幹細胞
ヒトはからだのなかに、皮膚や血液のように、ひとつ ひとつの細胞の寿命が短く、絶えず入れ替わり続ける 組織を保つために、失われた細胞を再び生み出して補 充する能力を持った細胞を持っています。
こうした能力を持つ細胞が「幹細胞」です。幹細胞と 呼ばれるには、次の二つの能力が不可欠です。
一つは、皮膚、赤血球、血小板など、わたしたちのか らだをつくる様々な 細胞を作り出す能力( 分化能)、 もう一つは自分とまったく同じ能力を持った 細胞に分 裂することができるという能力( 自己複製能) です。

幹細胞は加齢とともに減っていきます


エクソソームの役割
エクソソームは、細胞や細胞間に存在するだけではなく血液・髄液・尿等にも 存在して体内を循環し、細胞間の情報ツールとしての働きが あることから、 医学や美容分野で盛んに研究されています。


幹細胞培養上清とエクソソーム
再生医療の開発や治療が進むにつれ注目され始めた幹細胞を増殖させた培地
これを“上清液(順化培養液)”といい、再生美容や次世代 のコスメ開発にも活かされるようになりました。
上清液の有効成分はEGFやFGFといった成長因子、SOD
(Super Oxide Dismutase/活性酸素を分解する酵素)、ペプ チド・サイトカインなどと言われていましたが、
近年その一番の功労者は“エクソソーム”なのではないか・・・というデータが出てきました。
弊社では身体のどこに対しても有効で定着しやすい脂肪由来の幹細胞順化培養液を主に製造・販売していますが、
この上清 液にはエクソソームが多く含有されています。

幹細胞治療による具体症例
薄毛改善

首の横シワ改善

ニキビ跡改善

ハリ・ツヤ改善

施術感想
- ほうれい線が薄くなりました。肌に張りが出て、細胞が若返った感じがした。(60代女性)
- 肌質が良くなった(手触りがツルンとした)感じがする。(50代女性)
- 瞼の垂れ感が軽減されたのか、視界が開けた感じがする。(50代女性)
- 寝起きが良く体が軽い感じでした。(50代男性)
- お腹の中が動く感じがしました。翌朝、久しぶりの快便でした。(50代男性)
- 寝起きが良く体が軽い感じでした。(50代女性)
- 表情に艶が増しました。(40代女性)
- ツルツル感が増しています。(70代女性)
- 疲れが翌日まで残らなかった。(40代男性)
このような方におすすめです
- お肌のハリを取り戻したい
- シミやくすみを改善したい
- 認知症・物忘れ・糖尿病・糖尿病三大合併症(網膜症・神経障害 腎症)の改善・肝機能障害の改善・頚椎症や腰椎症による末梢神 経障害の改善・疲れやすさの改善・肩こり等の改善・育毛や発毛 の促進をしたい・自己再生能力を高めたい
期待される効果・効能

料金について
月1回プラン
初月
針なし注射器+エクソソーム2㎜ 1回分
199,500円(税込)
2ヵ月目から
エクソソーム2㎜ 1回分
49,500円(税込)
【6ヶ月おまとめ購入パック】
初月
針なし注射器+エクソソーム2㎜ 1回分
440,000円(税込)
2回目から
エクソソーム2㎜ 1回 6ヶ月分
290,000円(税込)月2回プラン
初月
針なし注射器+エクソソーム2㎜ 2回分
238,000円(税込)
2ヵ月目から
エクソソーム2㎜ 2回分
88,000円(税込)
【6ヶ月おまとめ購入パック】
初月
針なし注射器+エクソソーム2㎜ 2回分
640,000円(税込)
2回目から
エクソソーム2㎜ 2回 6ヶ月分
490,000円(税込)
※施術の際の診察料・カウンセリング料が含まれます。
※点滴量はカウンセリング時にご相談のうえ、決定させていただきます。